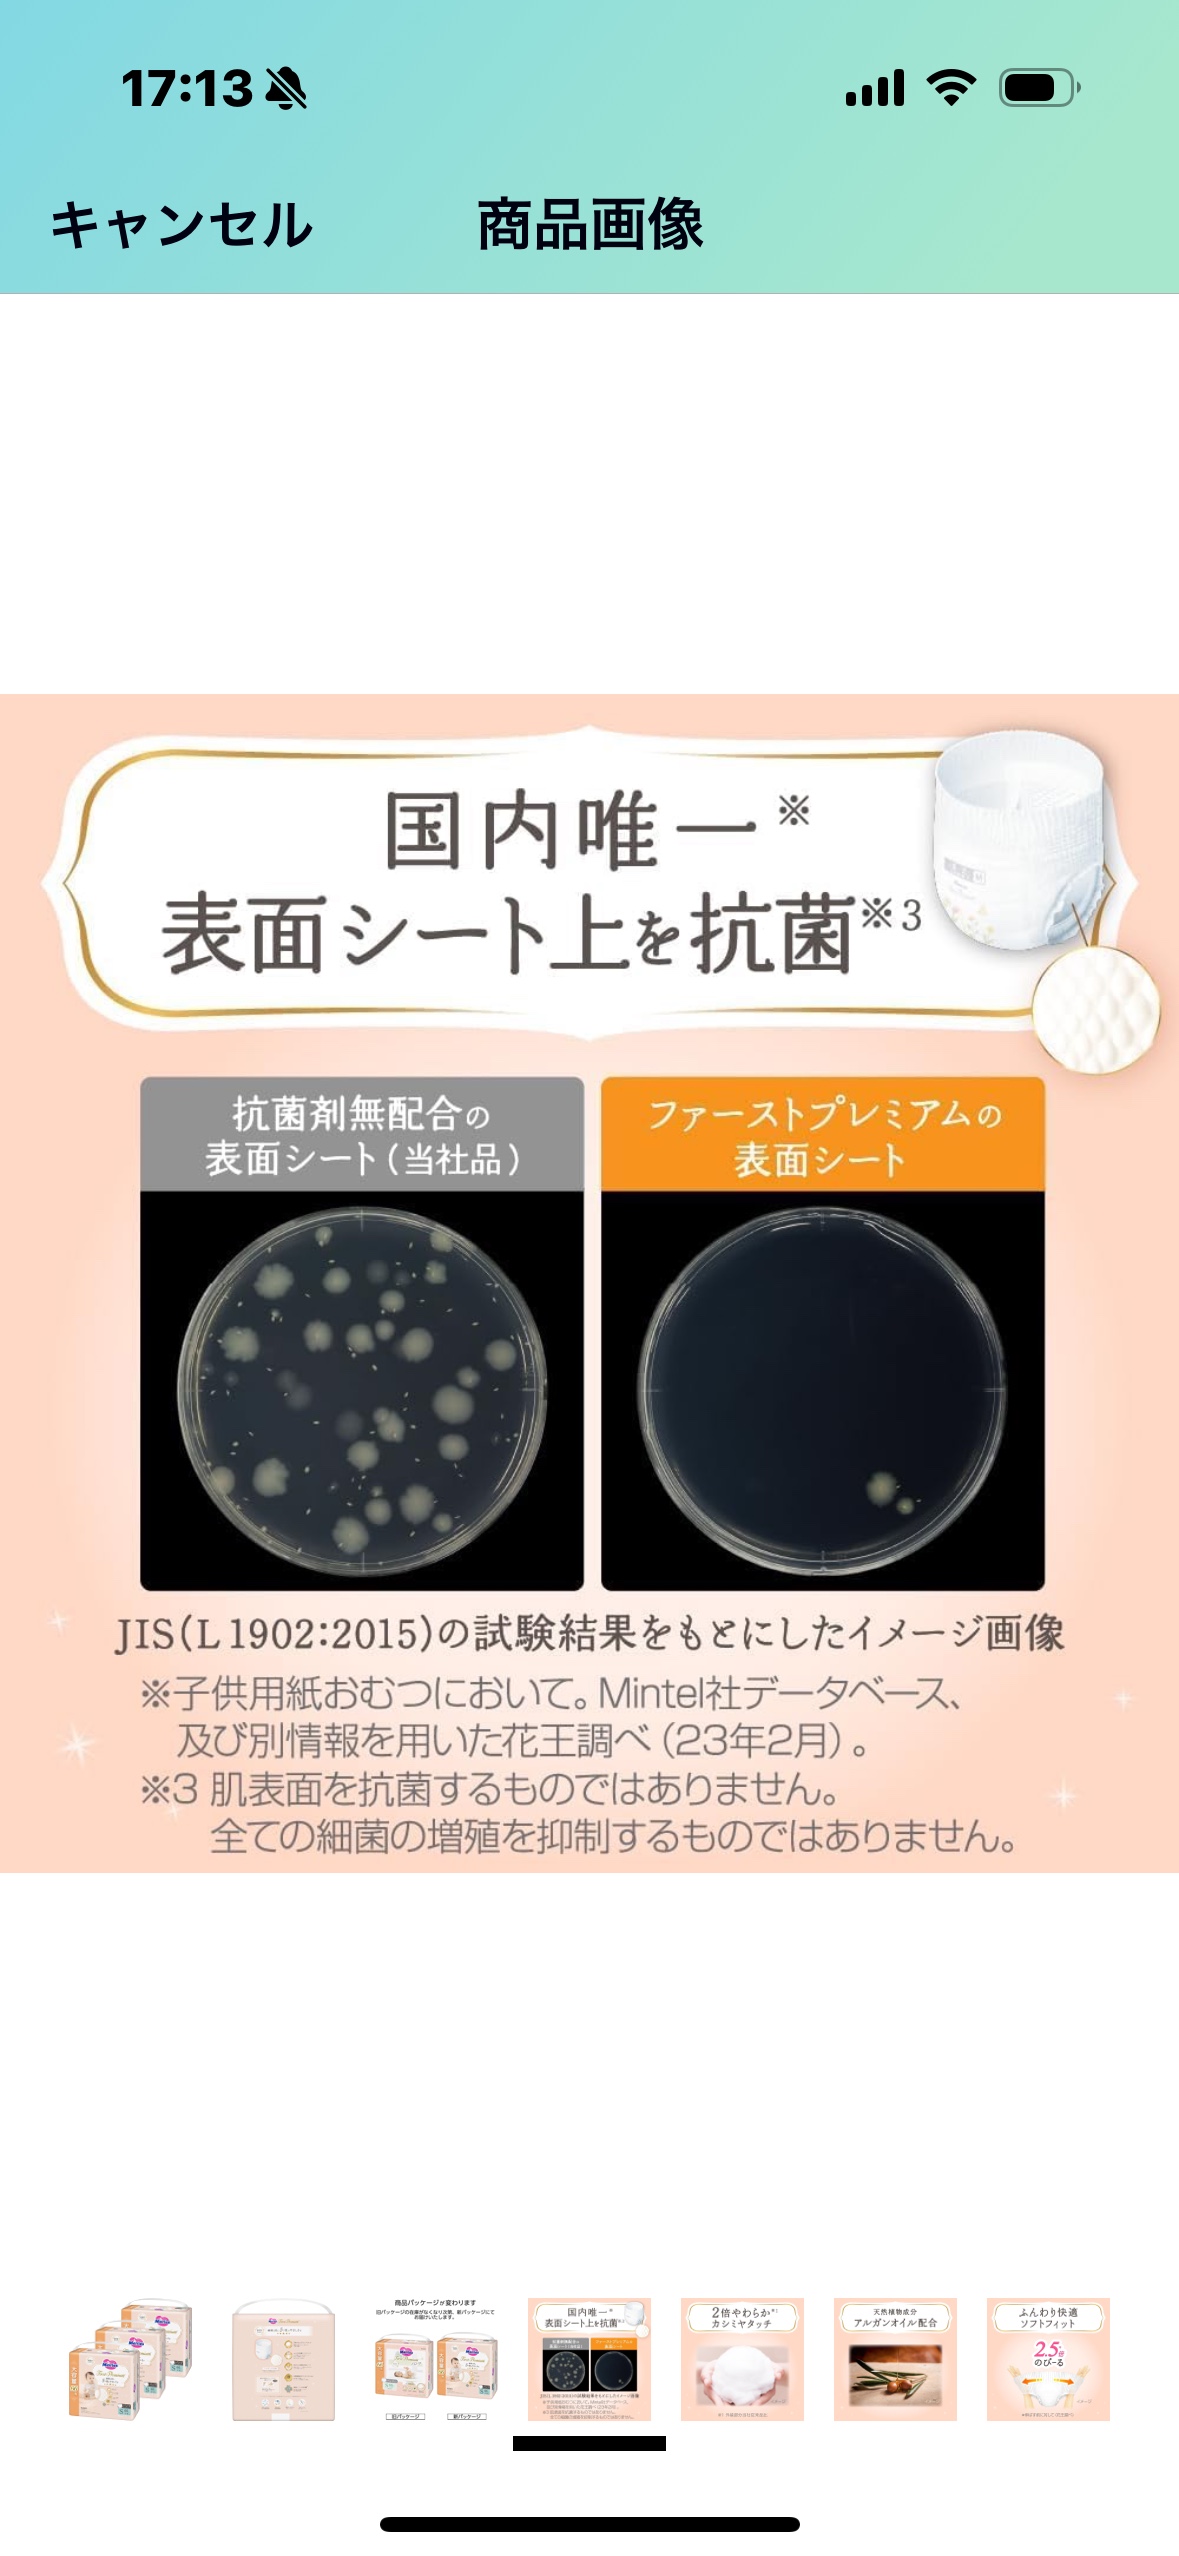

他でも出品しましたので早く纏まった方になります。 段ボール新品未開封品(定価5800円送料別)ですが2300円引きの3500円です! 間違えてSサイズを購入してしまった為の出品です。 世田谷区、太田区、目黒区、川崎市高津区辺りまででしたらご自宅近辺まで車でお届け相談できます。
- 商品の状態新品・未使用
- 年齢・月齢7ヶ月〜2歳
取引はアプリでのみ可能です。
ダウンロードしてご利用ください。
ダウンロードしてご利用ください。
人気商品
すべて見るベビーカー用傘スタンド
100円
玉川
トミカ ミニカー 4台セット
500円
世田谷
ベタベタブロック 知育玩具
500円
船橋
それいけ!アンパンマン 入れよう!開けよう!できるかな? かぎいっぱい育脳パズル
900円
船橋
ベビービョルン ベビーキャリア ハーモニーの抱っこ紐
8,000円
用賀
予約中
ストッケ トリップトラップ ベビーチェア
2,700円
弦巻
予約中
ストッケ ベビーチェア
7,000円
船橋
nadole 三輪車 水色
5,700円
世田谷
もぐらたたき&ビリビリDr.ゲーム、危機一髪ゲーム
400円
船橋
ベネッセ おしゃべりめざましコラショ
譲ります(0円)
松原
防寒ブーツ *16cm
1,000円
船橋
おむつようゴミ箱
譲ります(0円)
赤堤
【新品】サンリオイングリッシュマスター Lesson 51-60
9,999円
岡本
ディズニー ジグソーパズル 500ピース ミッキー
900円
砧
ジェラートピケ ぬいぐるみリュック
500円
上馬
カトージ ベビーサークル
2,500円
駒沢
ベビー布団セット ミニサイズ
4,000円
用賀
リッチェル 補助便座
200円
桜丘